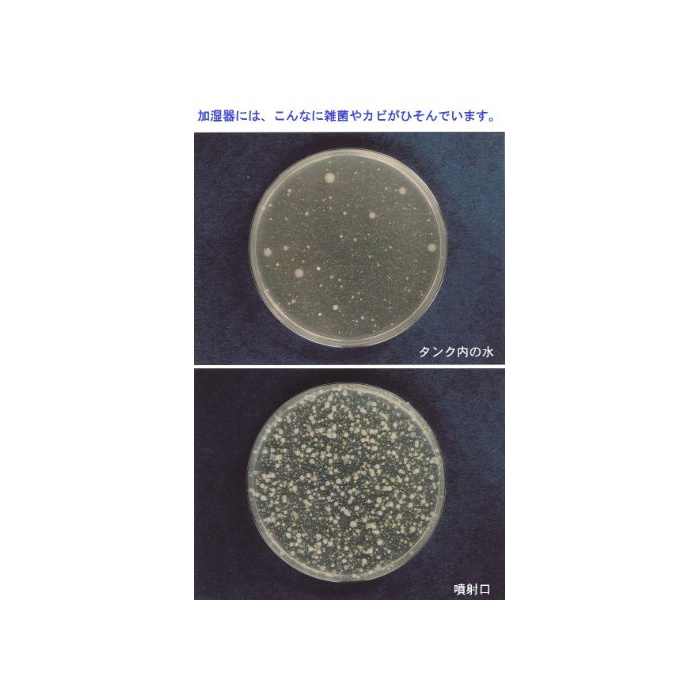

PRODUCT NAME
《고짓토》 가습기 탱크의 제균제
PRODUCT CODE: PROD50112381
PRODUCT INFORMATION
원본상품명: コジット 加?器タンクの除菌? ラベンダ?
사이즈:폭3.9×(길이)깊이3.9×높이12cm
중량:0.13kg
재질:성분/lavender 엑기스《아자디라쿠친》(니므 오일)대두 엑기스 곡물 엑기스계 면활성 제 수
원산국:일본
※팩키지 디자인은 예고 없이 변경 될 수 있습니다
Technical Details
Product Details
Package Dimensions
Width : 2.76 inch
Height : 1.18 inch
Length : 6.69 inch
Shipping Weight: 2.08 ounce (View shipping rates and policies)
ASIN : B00FB047JO